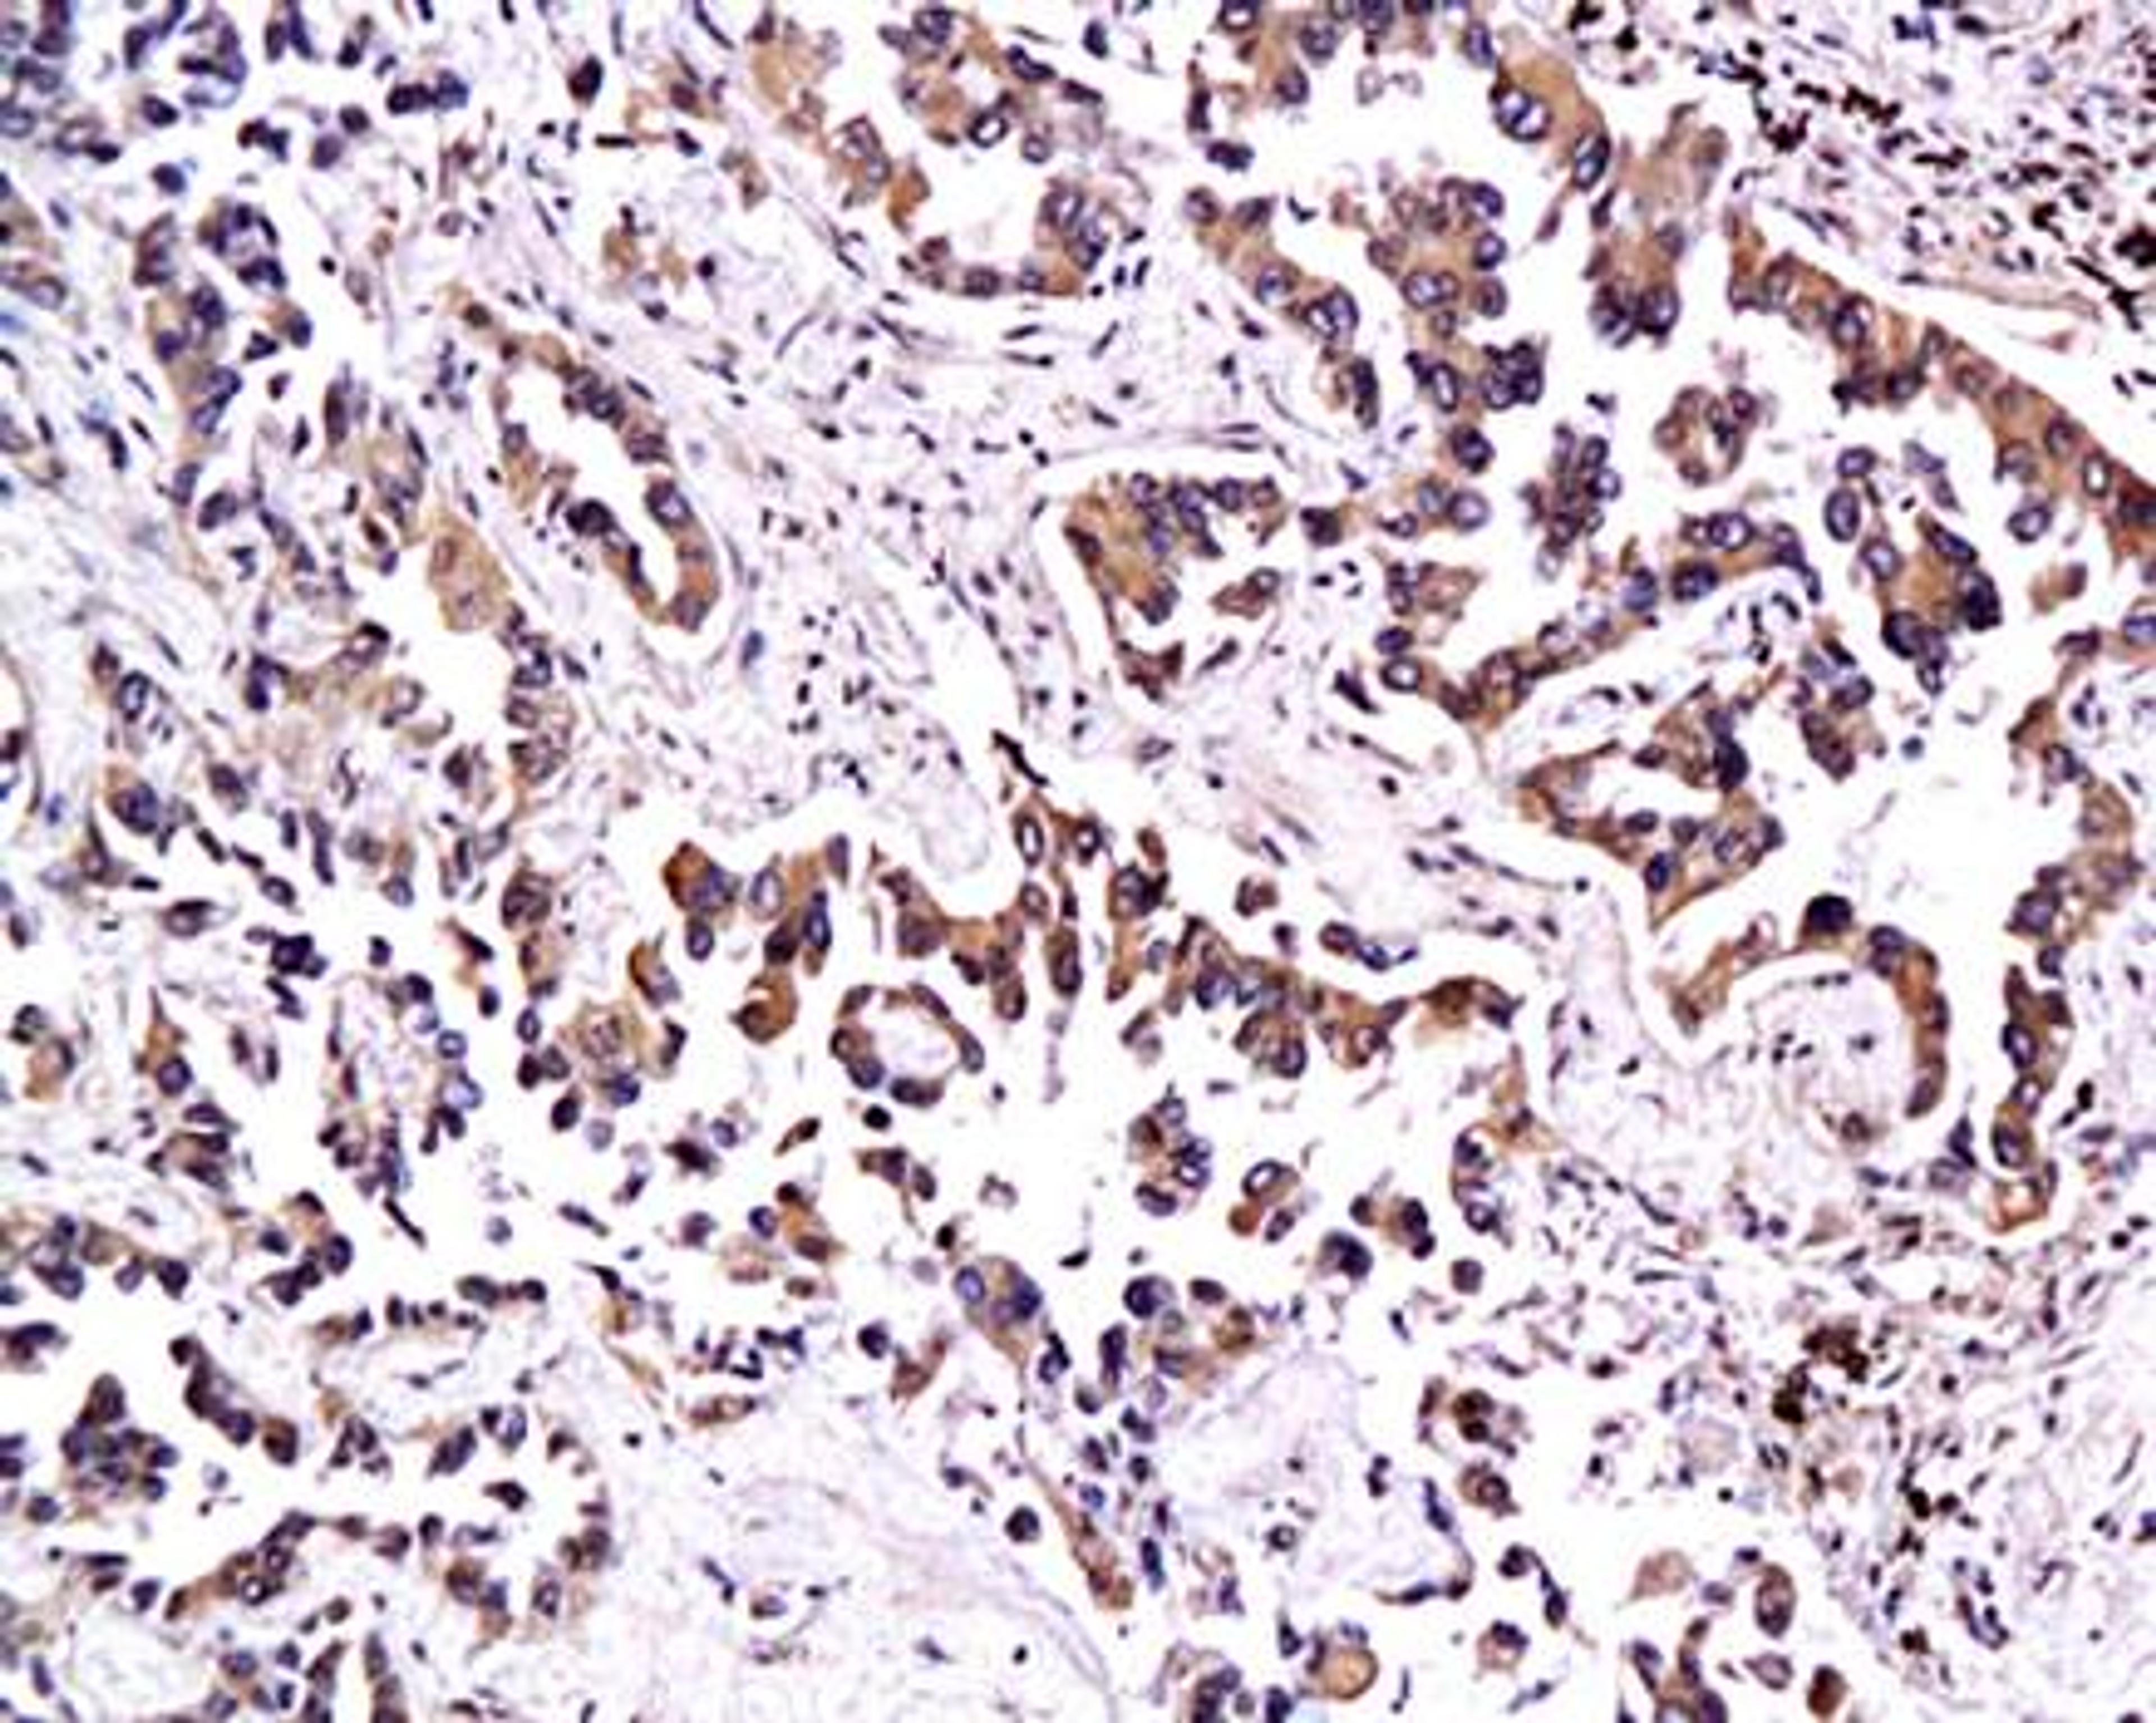
Immunohistochemical analysis of paraffin-embedded human lung adenocarcinoma tissue using Thrombomodulin antibody

Product & ReviewsAntibodies
Thyroxine 4 antibody
Product Details
- Cat. No.
- orb11479
- Type
- Primary Antibody
- Clonality
- Polyclonal
- Host
- Goat

The supplier does not provide quotations for this antibody through SelectScience. You can search for similar antibodies in our Antibody Directory.
Description
Goat polyclonal to Thyroxine 4
Biological Information
- Clonality: Polyclonal
- Host: Goat
- Reactivity: Not Species Specific
- Isotype: IgG
Handling
- Quantity: 100 µg, 200 µg, 25 µg (Trial Size)
- Storage: Store at 4°C for up to two weeks. For long term storage, aliquot and store at -20°C, avoid freeze/thaw cycles.
- Buffer: PBS (without Mg2+ and Ca2+), pH 7.4, 150mM NaCl, 0.02% sodium azide and 50% glycerol
Applications
- ELISA (ELISA)